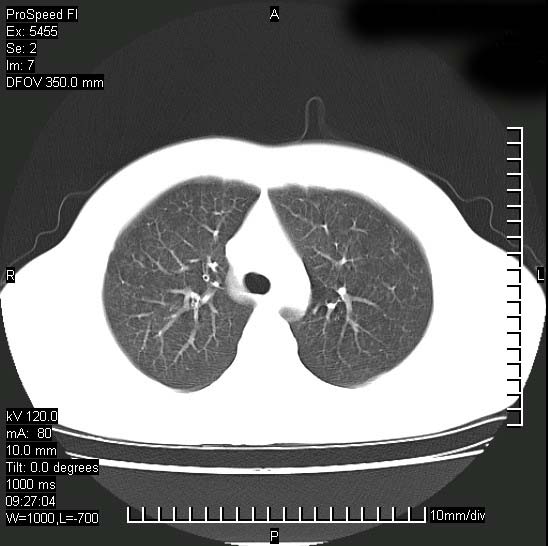

以下是引用zjzjr在2008-12-3 20:50:00的发言:[br]考虑泛细支气管肺炎,建议进一步检查除外肺出血性疾病如含铁血黄素沉着症、肺肾综合征等。
以下是引用zjzjr在2008-12-3 20:50:00的发言:[br]考虑泛细支气管肺炎,建议进一步检查除外肺出血性疾病如含铁血黄素沉着症、肺肾综合征等。
以下是引用光线在2008-12-3 20:19:00的发言:[br]双肺间质性改变。
| 欢迎光临 医影在线 (http://bbs.radida.com/bbs/) | Powered by Discuz! X3.2 |